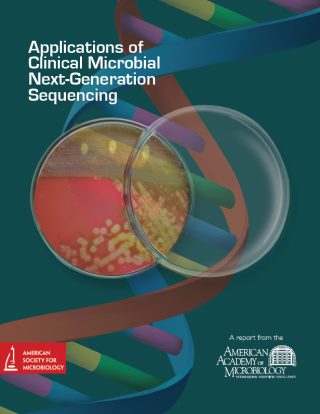
Cover of Applications of Clinical Microbial Next-Generation Sequencing

Next-generation sequencing (NGS) has the capacity to provide crucial clinical benefits in patient care, patient outcomes, and public health, however, clinical laboratories must find ways to overcome operational, technical, regulatory and strategic challenges in order to effectively employ NGS-based diagnostic tests. The Academy convened a colloquium on this topic in April, 2015. Beyond the potential lifesaving impact of NGS methodologies, the report examines the main deterrents and shortcomings of the technology such as the data analysis and management pipelines, regulatory concerns and reimbursement issues, and the creation and maintenance of curated and secure databases. The report, titled Applications of Clinical Microbial Next-Generation Sequencing, provides recommendations and suggestions for combating these current limitations to implement NGS in clinical settings.
Citation
Weinstock G, Goldberg B, Ledeboer N, Rubin E, Sichtig H, Geyer C. 2016. Applications of clinical microbial next-generation sequencing.
Contact Information
Academy Staff, academy@asmusa.org